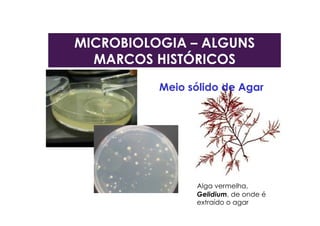
Alga vermelha,
Gelidium, de onde é
extraído o agar
Meio sólido de Agar
MICROBIOLOGIA – ALGUNS
MARCOS HISTÓRICOS
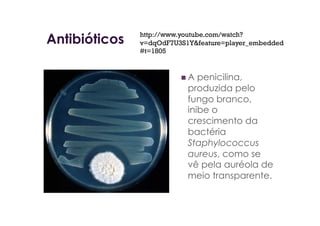
Antibióticos
 A penicilina,
produzida pelo
fungo branco,
inibe o
crescimento da
bactéria
Staphylococcus
aureus, como se
vê pela auréola de
meio transparente.
http://www.youtube.com/watch?
v=dqOdF7U3S1Y&feature=player_embedded
#t=1805
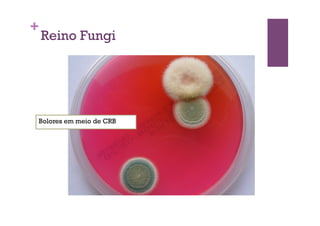
+
Reino Fungi
Bolores em meio de CRB
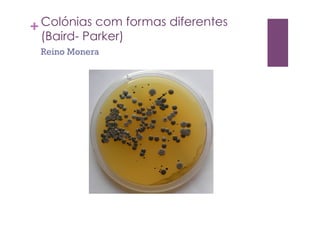
+Colónias com formas diferentes
(Baird- Parker)
Reino Monera
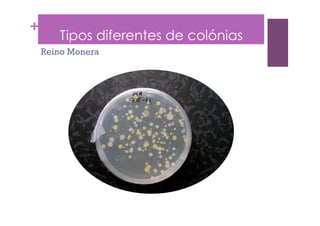
+
Tipos diferentes de colónias
Reino Monera
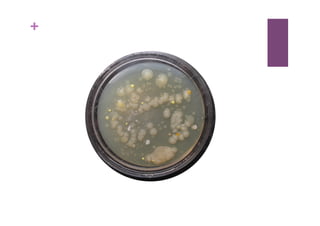
+

O documento discute a ciência da microbiologia, incluindo os principais tipos de microorganismos como bactérias, fungos, protozoários e vírus. Também descreve as áreas da microbiologia e alguns marcos históricos importantes como as descobertas de Hooke, Leeuwenhoek, Pasteur, Koch e Fleming.